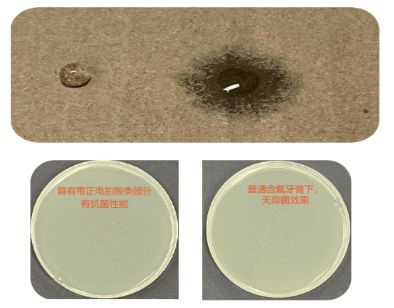

近日,国内儿童分龄洗护领导品牌兔头妈妈获得全球知名增长咨询公司弗若斯特沙利文权威认证,兔头妈妈奥拉氟防蛀牙膏荣获2023年“全国高端儿童防蛀牙膏销量第一”。认证背后是行业、市场以及消费者的多重信赖。

2022年,兔头妈妈首次为国内儿童防蛀牙膏市场引入德国有机奥拉氟成分。经科学实验对比,德国有机奥拉氟相比不含氟或仅添加氟化钠的牙膏,包裹性和延展性更强,可以深入清洁不易清理的牙齿间隙,是普通氟防蛀力的2.18倍。这一优势为儿童刷牙存在不好好刷、刷不干净的情况提供了解决思路。
近日,对于这一优势,兔头妈妈被投诉存在虚假宣传或夸大产品功效引人误解。经核实,杭州市余杭区市场监督管理局目前对该起投诉完结,兔头妈妈不存在虚假宣传,故投诉不予成立。
与此同时,关于奥拉氟是否是“智商税”的讨论再次掀起。其实,去年9月,兔头妈妈携手中国口腔清洁护理用品工业协会,联合主办了2023儿童口腔健康发展高峰论坛。会上,中国牙病防治基金会专家学者对兔头妈妈奥拉氟防蛀牙膏表示认可,也肯定了奥拉氟牙膏相较传统含氟牙膏的有效性。此外,江南大学化工与材料工程学院副教授洪流更是通过实验室数据,清晰对比了两种氟作用效果,结果显示,奥拉氟分子结构比较特殊,延展性更强;奥拉氟分子结构中的胺基,具有更好的协同杀菌作用。
其实,兔头妈妈不仅通过产品力赢得消费者口碑,更是作为表率赢得行业认可,据悉,兔头妈妈为“中国口腔清洁护理用品工业协会正式常务理事单位”。至今,兔头妈妈是中国口腔行业协会常务理事成员唯一专注做口腔的母婴品牌,同时也是中国口腔护理用品标委会技术成员单位,参与制定儿童口腔产品标准。

儿童口腔护理健康被高度重视的今天,市场上产品质量良莠不齐,“纯奥拉氟”的伪科学宣传甚嚣尘上,引起消费者恐慌,也影响着行业的健康发展。实际上,根据ECHA(欧洲化学品管理局)、SCCS(欧盟消费者安全科学委员会)的数据及化妆品安全评估技术导则的计算方法进行安全评估,纯奥拉氟使用对象为1-6岁范围内的儿童是无法通过安全性评估的。
目前,兔头妈妈联合SGS通过347项安全测试和欧盟化妆品安全测试,完成对所有原料及整体配方进行安全性评估,成为国内首家且是唯一一家完成奥拉氟牙膏配方安全评估的品牌。
面对行业乱象,兔头妈妈始终相信产品才是硬道理,坚持以科技赋能打造高品质产品,确保科学传播言之有物,言之有据。未来也将以行业领头者的身份,积极推动行业质量标准体系,以高质量、高要求为准,打造行业良性生态。
转自:中国网
【版权及免责声明】凡本网所属版权作品,转载时须获得授权并注明来源“中国产业经济信息网”,违者本网将保留追究其相关法律责任的权力。凡转载文章及企业宣传资讯,仅代表作者个人观点,不代表本网观点和立场。版权事宜请联系:010-65363056。
延伸阅读